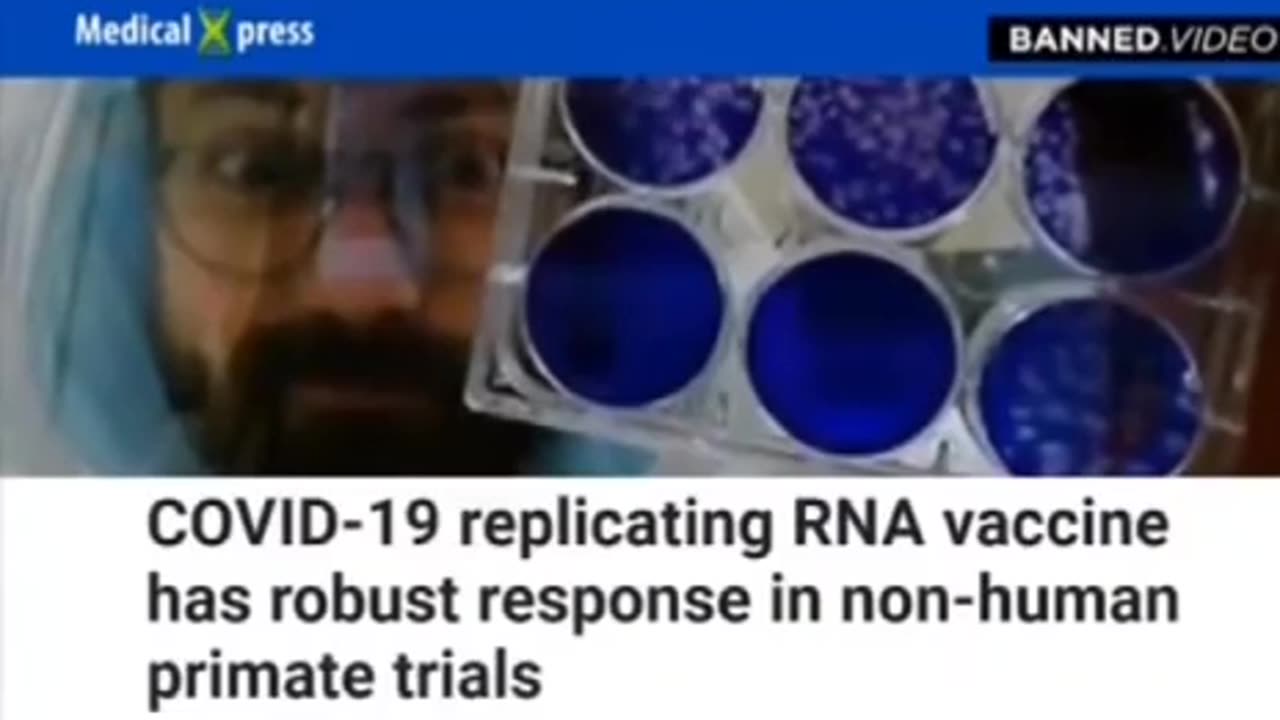
Reese report - 5G + covid

Premium Only Content
This video is only available to Rumble Premium subscribers. Subscribe to
enjoy exclusive content and ad-free viewing.
Reese report - 5G + covid
Loading comments...
-
 1:53
1:53
GreenMan Studio
13 hours agoGAMER DAD STARTER PACK COMMERCIAL w/Greenman Reports
2.29K -
 48:09
48:09
TheCommonSenseShow
17 hours agoNEW MEDIA HAS CRUSHED MSM IN RATINGS!
3971 -
 LIVE
LIVE
BEK TV
22 hours agoTrent Loos in the Morning - 2/04/2026
212 watching -
 30:39
30:39
Liberty Vault
22 hours agoCandace Owens Exposes the DARK TRUTH About Israel, Trump, and Thiel in the Latest Epstein Files
31.5K49 -
 14:02
14:02
stateofdaniel
1 day agoMamdani HECKLED by His Own Supporters: OUTRAGE Over Garbage Blizzard Response - Nashville DEVASTATED
7.39K22 -
 11:52
11:52
Actual Justice Warrior
1 day agoIt's OVER For The Transgender Movement
27.3K38 -
 10:52
10:52
Code Blue Cam
1 day agoWhen You’re Too Drunk to Realize You Crashed into a Cop
12.5K10 -
 12:21
12:21
Isabella Moody
10 hours agoDave Smith and Nick Fuentes' BRUTAL Friendship Collapse Caught LIVE!
16.1K34 -
 50:52
50:52
Man in America
12 hours agoEpstein Files Reveal Human Cloning, MK-Ultra & Rothschilds Hiding HITLER??
258K114 -
 1:48:59
1:48:59
Badlands Media
17 hours agoDEFCON ZERQ Ep. 029: Epstein Files, WITSEC, and the Architecture of Control
113K77